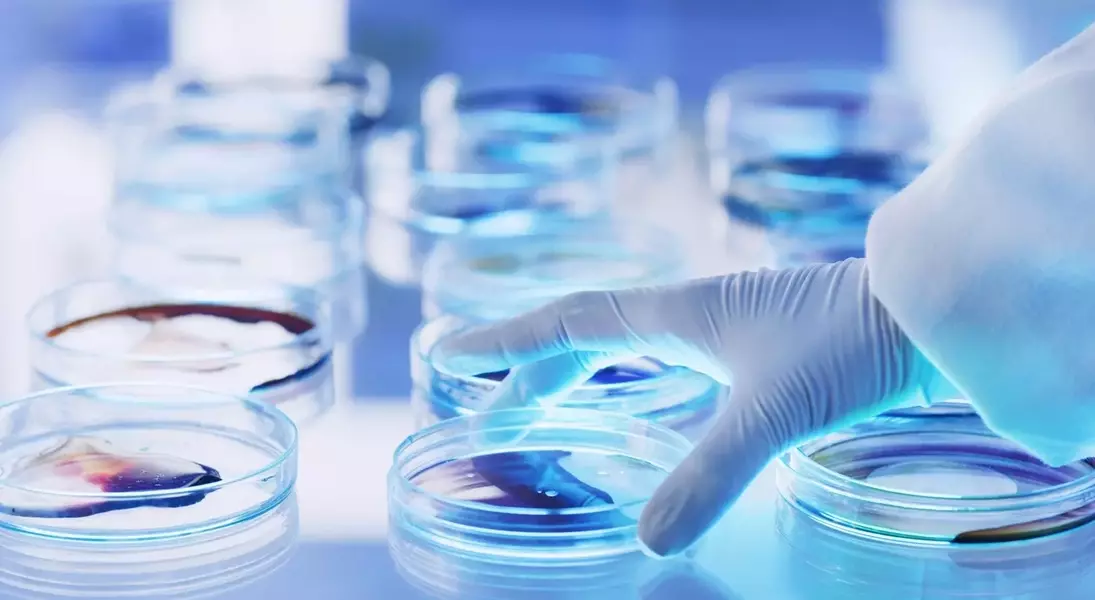
Single Slide

Pioneering Pancreatic Cancer Treatment: Immuneering's Breakthrough
Immuneering's Promising Clinical Results: A Deeper Look at Atebimetinib
Immuneering Corporation continues to be a top recommendation, particularly after the release of its 12-month overall survival (OS) data for atebimetinib. This therapy, when combined with mGnP, has shown remarkable efficacy in first-line treatment for pancreatic cancer, achieving a 64% survival rate. This figure stands in stark contrast to the typical 35% OS rate observed with standard-of-care treatments, effectively nearly doubling the survival duration for patients.
Market Reaction Versus Scientific Reality: Dispelling Misconceptions
The market's response to the OS data revealed a misunderstanding, as some perceived a decline in efficacy when comparing 9-month and 12-month data. However, such direct comparisons can be misleading due to variations in study populations and follow-up periods. Immuneering's MEK inhibitor operates through a highly differentiated mechanism, which was not fully appreciated by the market, leading to an unwarranted dip in share price. The company's innovative approach targets specific molecular pathways, offering a more precise and effective treatment option for a notoriously difficult-to-treat cancer.
Financial Stability and Future Milestones: A Clear Path Forward
Immuneering is in a strong financial position, with sufficient capital to fund its operations through 2029. This stability provides a solid foundation for ongoing research and development. The company anticipates several significant milestones that could further boost its valuation, including the release of expanded Phase 2a data in the first half of 2026. Additionally, data from the pivotal Phase 3 MAPKeeper 301 trial are expected in 2028, which could solidify atebimetinib's place as a cornerstone therapy for pancreatic cancer.
Strategic Investment for Long-Term Growth in Oncology
For investors looking at the biotechnology sector, Immuneering Corporation presents an attractive opportunity. The robust clinical evidence, the distinct therapeutic advantage of atebimetinib, and a well-managed financial runway suggest considerable growth potential. As the company progresses through its clinical trials and approaches commercialization, it is poised to make a significant impact on pancreatic cancer treatment, offering hope to patients and value to shareholders.
